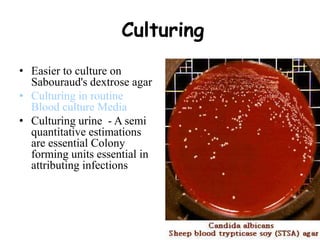
Culturing
• Easier to culture on
Sabouraud's dextrose agar
• Culturing in routine
Blood culture Media
• Culturing urine - A semi
quantitative estimations
are essential Colony
forming units essential in
attributing infections

This document provides an overview of systemic and opportunistic mycoses. It defines systemic mycoses as deep fungal infections caused by soil-dwelling dimorphic fungi that are accidentally inhaled. The main causative agents described are Blastomyces dermatitidis, Paracoccidioides brasiliensis, Coccidioides immitis, and Histoplasma capsulatum. Opportunistic mycoses occur in immunocompromised individuals and the most common causes are Candida species, Aspergillus species, and Cryptococcus neoformans. Key clinical features, laboratory diagnostics including microscopy, culture, and serology, treatment approaches, and important epidemiological details are summarized